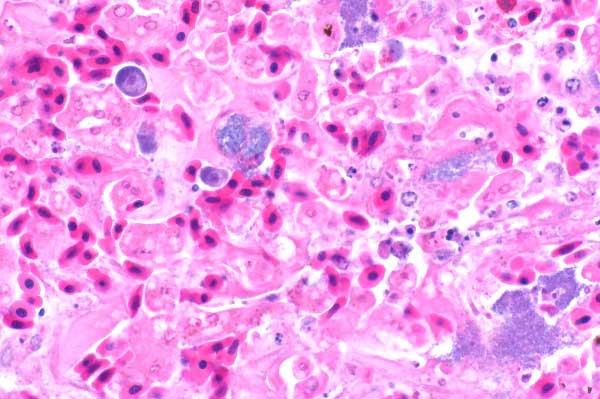

| 40x | Hematoxylin and Eosin | ||||
| Close Window | Macro View | Back | ||
|
Many hepatocytes are individualized, rounded, and hypereosinophilic with pyknotic and karyorrhectic nuclei (necrosis). Note the presence of scattered basophilic colonies of coccobacilli and few amebic trophozoites.
|
||||
|
|
||||
| Return | ||||
|
Many hepatocytes are individualized, rounded, and hypereosinophilic with pyknotic and karyorrhectic nuclei (necrosis). Note the presence of scattered basophilic colonies of coccobacilli and few amebic trophozoites.
|
||||